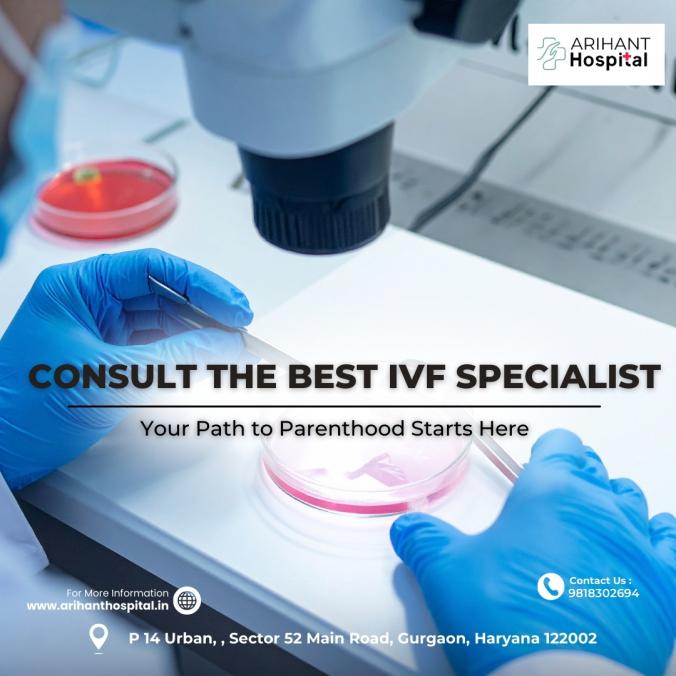
Thumb

Searching for the best IVF specialist in Gurgaon to help you start or grow your family? Get expert fertility care from a trusted specialist known for high success rates, personalized treatment plans, and compassionate support. With advanced IVF technology and years of experience in treating complex infertility cases, our specialist offers the right blend of science and sensitivity. Whether you’re just starting your fertility journey or exploring options after previous attempts, you’ll receive honest guidance and world-class care. Book your appointment today with the best IVF specialist in Gurgaon and take a confident step toward your dream of parenthood.